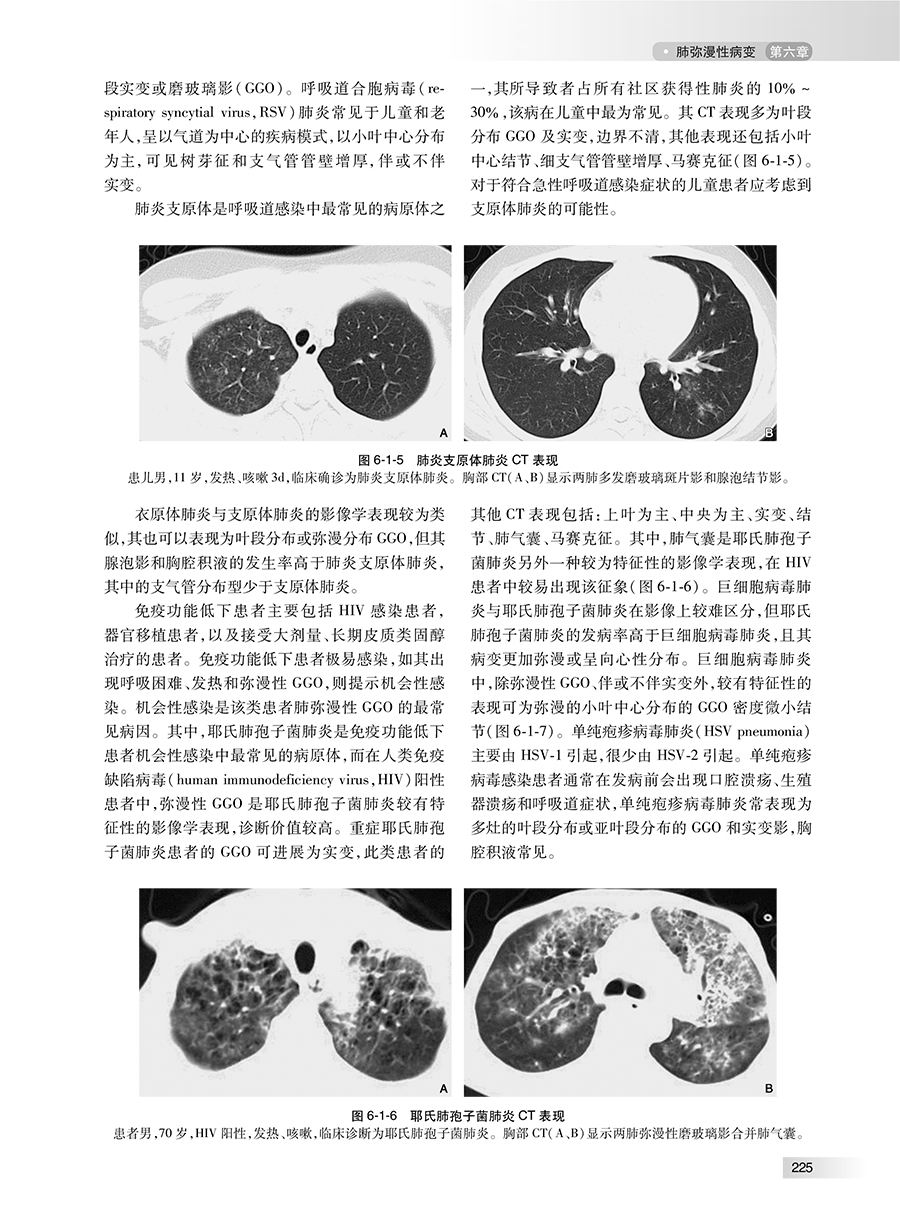

出版社: 人民卫生
原售价: 198.00
折扣价: 148.50
折扣购买: 中华影像鉴别诊断学——胸部分册
ISBN: 9787117369206

获得第十三届“中国医师奖”,曾担任国家自然科学基金生命医学部二审专家;被评为第二届辽宁省“医学名医”和第三届辽宁省“教学名师”,并入选辽宁省“百千万人才工程”百人层次,辽宁省第九届优秀科技工作者等;获得大连市先进工作者(劳模),大连市首批领军人才、第四批优秀专家和首批优秀科技工作者等;主持国家自然科学面上项目四项,主持和参加省市级科研及教学改革项目十余项;获得省部级和市级科研与教学成果奖十余项。
中华影像鉴别诊断学丛书暨中华临床影像征象库分为9个分册/子库:神经分册/分库,头颈分册/分库,胸部分册/分库,心血管分册/分库,消化分册/分库,泌尿生殖分册/分库,骨肌分册/分库,乳腺分册/分库,儿科 分册/分库。内容将基于国内大型三级医院权威专家的临床实战经验,跟踪相关领域国内、国际最新进展,关切专科医师、住院医师培养和临床研究生的核心需求。纸质书的主要内容包括:定义、病理基础、征象描述、相关疾病、疾病鉴别。每种征象附有诊断流程图、分析思路和误判防范等。临床影像征象库与纸质书的内容彼此呼应、关联,针对每种征象汇集相关疾病的临床病例和专家解读,完美体现科技图书出版的纸数融合。